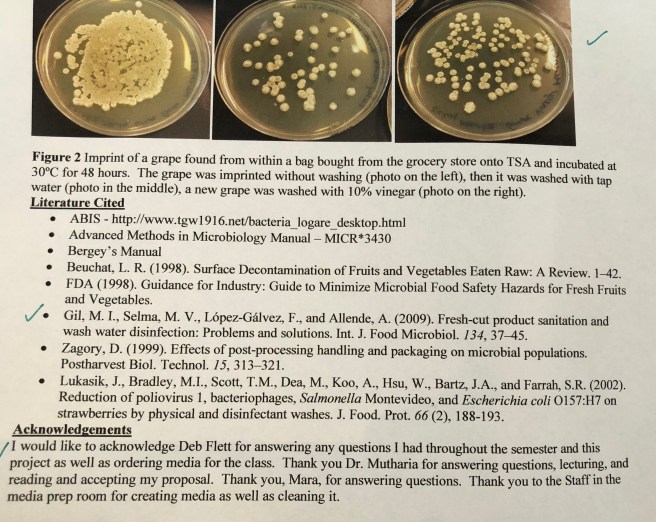
82C152BA-6880-4D6F-84E3-FD8A0C400ED1

FRIDAY, MAY 6, 2016
100 Things I Want To Teach My Daughter #76~ Love Your Children for whothey are, not for what you want them to be~
Love Your Children for who they are, not for what you want them to be~

Well Fox, as you know even from tonight’s chats this one was a challenge for me at times. We had a lovely walk this evening and I love our talks. I hope you always remember this conversation we shared tonight especially when you become a mommy~
As I was explaining to you earlier, when you have a child you automatically assume your baby is going to be “everything you’ve imagined”. Especially with you being a girl, I had just figured I’d have this bubbly little girl floating around the world with the happiest brightest smile I ever did see. I mean in my dreams long before you were even considered a twinkling light in my mind, I had always wanted a spunky, high-spirited little girl.
To my surprise, god had other plans for my perfect daughter~
Now I am not saying you were not happy, I know you had a wonderful childhood with not too many worries or concerns related to family life, stability or safety. I am not dismissing the seriousness of some things you endured being a sister to medically fragile brother. You DID NOT have it easy by any means and the stress at times in our home was deafening.
I am proud however that through it all, we still managed to remain a family. We always put each other first and your happiness was always of the utmost importance.
It really is so nice that we can look back at you as a child and chuckle.
Tonight you asked me if I felt due to your brother receiving so much outside attention from others that maybe that had an effect on your personality and demeanor.

(This was one of those times when your Brother was getting lot of attention. It was Make a Wish for him, and you were having none of it)
Maybe Fox it did, I do know at times you resented him for all the attention he got. I know it must have been very hard to watch even strangers come up and talk to him. Give him their blessings, some even passed him money. We did our best with the effects that may have had on you. If you remember, anything Braden received he would have to share, or donate to charity.
We really did try to compensate for the lack of societies awareness of your presence. Please know, deep down I loved that they saw you as a “normal” child. All I ever wanted was a “normal” family.
If you really think about it, how do you think Braden felt? If anything it made him feel different from us. I didn’t expect you to understand that as a child, we did our best~
I find it hilarious that your old friends, and the new ones you’ve met have discussed your b**ch face with you. Some admitting they were scared of you. I LOVE that Fraser called you a “Miserable Git” pretty much through all your school years.

Here you were with all your excitement during your school Christmas play, lol sorry fox..its just too cute!)

LOL…the ones who know you, know better. I admire the ones who have stuck by you, the ones who accept you for who you are. Regardless of what you are portraying on the outside, your true friends know you on the inside. They are able to share in your excitement even if you have a “face on”. LOL

{I remember doing this photo shoot, it was for my practice but also an encouraging time to show you how to relax and smile. lol…it went well 🙂
Now, I know you are not a miserable person. I also know you are a whole lotta shit kickin fun. You are a straight shooter who sees through bullshit faster than anyone can smell it. You don’t work to please anyone, and you are not too concern of what others think of you. I LOVE THAT!
But it has taken me a very long time to get here.
You see, I use to worry all the time. Why doesn’t my daughter come running out of gymnastics laughing and screaming, happy, smiling and dancing all the way to the van? NO, my lil’freckled fox couldn’t give a fuck that gymnastics was over, she wanted her juice box and that was the extent of her happy thoughts.

(Well here’s classic example of you lack of enthusiasm with gymnastics. As you can see, you didn’t have your mind in it. You had other things going on, obviously you were thinking about getting the hell out of there as soon as possible. lol)
Tonight you had the best possible answer ever and Fox you continuously amazing me with your smarts, analogies and life knowledge.
I asked you why (in a joking way) “why didn’t you ever come out of gymnastics or skating lessons laughing and smiling?”. Your response was classic Kail….”Cause I already reached happy”, I didn’t need others to know it.
Happiness on the inside is the secret to all success and you had that figured out long before anyone else I know.

Our beautiful girl~
You out of anyone on this earth have taught me so much about life~
It has taken me well into my 40’s to understand I do not need to impress anyone. That I am not responsible for anyone else’s happiness. Here you are a 4 year old little girl with the confidence of a lion. Of course at the time I was insecure and couldn’t figure out why my brilliant little girl wasn’t skipping out of the gym grabbing at my purse for your “after activity snack”. You have always been the calm cool collected girl. Sometimes I wanted that little spirited child, the one smiling, running and hopping for attention. That just wasn’t you…and I had to learn to love that~
It has taken me some time to realize that nature sometimes over rules nurture while parenting. You see, the traits you share are with your father. He too has never succumbed to pleasing people. That intimidates some, and you my darling have that natural ability. NEVER lose it. This is what will make you a successful woman in todays world.
In todays world of social media, selfies, show-offs and “look at me’s”, you are not effected by it. Not that there is anything wrong with “sharing” what you look like on Instagram. I just admire the fact that you don’t find it necessary. I love that~
So lets get back on track here. This post is written to leave you with some parenting knowledge, something I want you to always remember when you become a mom.
Love your children for who they are, not for what you want them to be~
Just because you may want your children to grow up and become professionals, models, brilliant scientists, doctors, or lawyers. It doesn’t mean its what they want. As long as you know they have the attitude that they can always better themselves through life experience, education and pursuing goals. If they are determined, independent, law abiding citizens. LOVE THEM.
As parents we all have hopes and dreams that our children will become successful, hardworking adults. Sometimes children have other plans, they become artsy, free-spirited individuals floating around society in a haze. LOVE THEM.
If you are confident in your parenting, and they have all the tools they need to define their own success…then my darling you have done a wonderful job. Let them find their own way in this world, let them leave their stardust everywhere.
Sometimes they will take longer to find themselves, that’s ok. If you provide an environment filled with love, trust and respect your children will always want to strive for a better life.
It is one of the hardest things as parents to do, allowing your adult children to pursue the dreams that you did not have for them. Its a loss, and sometimes we mourn the ideas we had specifically for them.
That includes all their choices and decisions, you must give them room to grow and develop into the lovely person they want to be. Like I said, it may not be what you had dreamt on the day they were born. However I promise if you choose to understand their wishes you’ll get to know them on a level you could only ever imagine. Be open to change, and love them regardless~
I love you my Freckled fox and you continue to make us proud.
My lovelies, until tomorrow good night and god bless~

Freckled Fox
Posted by Chrissy’s family life blog at 7:09 PM No comments: 
Email This
BlogThis!
Share to Twitter
Share to Facebook
Share to Pinterest
WEDNESDAY, APRIL 27, 2016
Playgrounds Were A Nightmares~ Accessibility has always been a battle
Do you have any idea how devastating it is for a parent of a physically challenged child to go to a park? Here’s a little secret….I did not look forward to going to the park with friends. It was NOT a good time for me.
WHY?
Because your children got too run around the playground and creative while my son had to be carried. Usually by myself or Paul. It was a very difficult time, and I am sure Braden had many frustrating moments due to the lack of accessibility in our parks.

You see its not that I hated being with my friends or their kids, it was how much work it entitled. All the other parents could pull up a chair, sit down and supervise their children while they played on the creative.
I wanted to watch my kid play~Not help my kid play
I had to constantly be up and down, in and out always available to that perfect little boy who just wanted to keep up with the others.
How could I not leap up when he called out too me..”Mommy can I go up there”, “Mommy can I swing on the swings?”, “Mommy can I go down the slide?” Of course I would jump up and bring him around the creative doing all the wonderful things the other three year olds were doing.
If there was a little tykes car on the street, he’d want to go in that. That would mean I had to lift him, and try to fit him in that little car while threading his legs into a working position. Once seated he’d want me to push him. That meant bending over, sweating in the heat of summer pushing this little guy whose legs would end up getting caught somewhere between place A and B. Then the tears would flow. Usually mine~
Now lets not make this all about me. I can guarantee you this, he certainly didn’t want me there either. If given a choice any little boy would not want their mother linger over them, carrying them, maneuvering him from place to place. Constantly carrying them while their little friends ran about playing tag or shooting their fake finger guns at one another pretending to shot the bad guy. It became a dependant relationship that neither of us would have wanted if given a choice. I could see the frustration on his face, it was a very difficult time in his childhood. Something that so many others take for granted.
I have witnessed the annoyed parent who begrudgingly gets up out of their chair to pass a towel to their wet child. Whining because their child is stuck on top of the creative and too scared to come down by themselves, so they have to get up off your lawn chair and lift them down. What I would have given to have had that choice. How very fortunate and blessed you are…and you don’t even know it.
Looking at those summer days today, some of these issues were faced in the best of environments. Well paved playgrounds were the ideal, however there were never any ramps or wheelchair accessible obstacles for him to play on.
Can you imagine how things went down when the playground was mulch covered or sported nice plush green grass, or even better the sand filled play ground. We down right avoided those, the water parks were horrendous as well. Pretty much had to get myself wet every time, he couldn’t use his electric mobility devices because they couldn’t get wet.
Once again, if we didn’t get up and participate in the activities, carrying Braden through the splash pad and water fountains he wouldn’t have that fun either. So forget sitting down with the other mom’s at the park. I just give thanks that I was a young mom. I had the energy at that time in life, well I had the physical ability but that doesn’t mean I wasn’t tired. That just means I willed the strength to make it happen.

But in all honesty I was tired, I was jealous that everyone else could sit down and relax while their kids burned off energy on the playground. The sun leaving kisses on their little faces, scraped knees, sticky fingers and dirty faces completed the day. Out like a light after dinner, smelling like the sweet scents of summer.
Is that selfish of me?
Even though I have the bravery today to speak the truth and share with you what it is like for parents of physically disabled children, I do believe there was many positive things that came out of it. In all honesty if you were to ask any parent of a special needs child I can guarantee there may be things they would love to change, but I know it would never be their child.
I for one, wouldn’t change a whole lot about my life. I absolutely love my family and who we are today.
The best of times was when it was just the four of us. (also my parents). We would play on the creative as a family, Paul and I didn’t need to worry about talking to others or drinking our coffee’s while they’re hot. We played with our children, because we had too, and most times wanted too. Paul would lift Braden up, and he would run all around the creative. Kailey and I trailing behind laughing and loving our family time. We’d wear these kids out and then grab an ice cream and head home. We always enjoyed our time out together as a family, I didn’t have to be jealous of anyone because all those parents watching us with our children were jealous of us. I could see it

I don’t want to come off in this post like playing in parks with my kids was not fun. I did enjoy spending time with my friends and their children. I am complaining about how challenging non-accessible playgrounds were/are for children with physical disabilities. I am expressing exactly how difficult it is for parents and their differently abled children who have to operate around wheelchair hating debris.
Having these hindrances in our lives, we did become quite crafty with outdoor play. Our imaginations became so important. We had to come up with ideas on how to encourage and incorporate out door play for Braden and his friends.

Winter time play with neighbours.

Neighbourhood kids playing with Braden and Kailey. They learned at a very young age how to incorporate Braden, I will love these Wadsworth kids for always being there for him.

Pool parties with friends, endless summertime days. Lots of candy and good times~

Water gun play…refilling the guns.

More pool parties…always a pool full of kids. As you can see Braden was independent with his friends. I was always close, someone had eyes on him at all times. The kids knew his fears and weaknesses but always made him feel safe.
Its one of those things that if we didn’t take charge and taught some of his friends how to include Braden in play…then how would they know?
We eventually bought Braden a power wheels jeep, this provided him with some mobility while outside.

Braden and baby Kayla at the park, just babies.
All the kids loved getting rides in that jeep. They became very creative, and attached wagon’s and buggy’s too it. I remember at times Paul would load that jeep into our van before leaving for work in the morning because I was having a play date at the park that morning with friends. I had great people in my life who would help me take the jeep out of the van, and then load it back up when we were leaving. He didn’t have to miss out on much, if the playground was paved he would have a blast.
Eventually we started bringing toys to the park, we loaded up our van with water guns, plastic toys, toy guns, racquets, balls, chalk, bubbles, action figures. Pretty much anything we could draw the neighbourhood and park kids in too play with Braden. It was a lot of work, but when those kids saw our wagon coming filled with toys. They’d come running. Genius.
Then we put in a in ground pool. That was another good idea.

We had countless pool parties, school year end parties, special engagement parties and just “lets get together” parties.
We also put in a hot tub, in the winter time it was wonderful. Braden could have friends over and they could spend time outside in the hot tub together.

Having all the kids come to our house worked great. It was ALOT of work, and we were exhausted parents. But we did it. He did not miss out on anything. Paul and my brother built a creative in the back yard as well. It was an all wooden structure that had stairs that were laid out perfectly for Braden so he could do them himself. It was amazing.

On top of the creative, he could crawl around the whole thing by himself. I had to stay close but at least he was independent with friends. There was nothing sweeter than hearing him laughing with his buddies, you never knew what he was up too.

All his friends could run around, but if he played his cards right he could always control the play. He learned very young how to keep those kids interested and intrigued with playtime at our house. Even in the pool they knew exactly how to keep Braden integrated.

During a school play, he was a part of everything. The kids made sure of it.
For all the negatives we always had ten positives. I truly have not much to complain about. The people in our lives were wonderful. The kids who played and entertained Braden through his childhood were honestly a god send. That included our neighbourhood kids as well. We had the best set up here on Wadsworth Cres.
The purpose of this blog post is too let people know, that our communities are not set up for children in wheelchairs. We have a long way to go, so many changes need to be made. My advice to you, if you are a parent reading this post and you are at a park and see a child in a wheelchair. Please make an effort to bring your child over to them. Ask them if they’d like to play. Ask the parent or guardian what can we do to make it easier for their child too join in.
Having the time today too go through all these memories, I look back and wonder how we did it. My hopes would be too inspire you to make a difference.
Well my lovelies, I hope you are all doing well. Until next time good night and god bless~